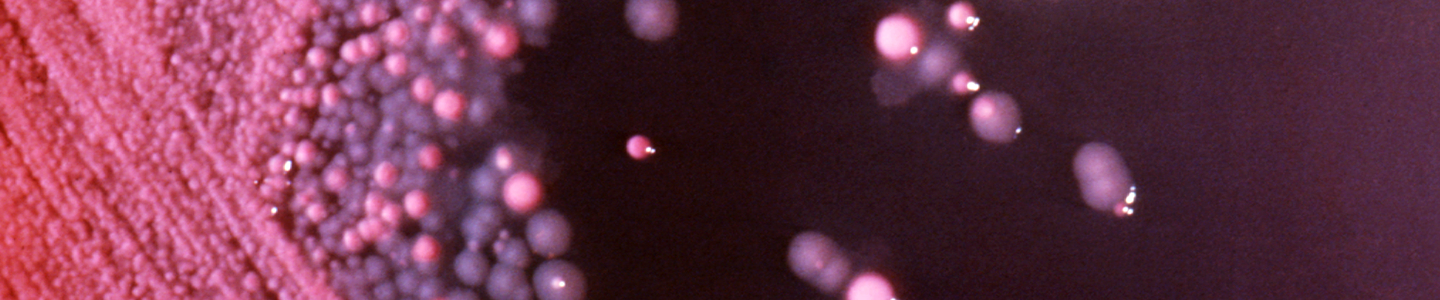

Applications
Help your microbes divide and conquer.
You can’t see them, but microbes are everywhere! Viruses, fungi, yeasts, protozoa, algae, bacteria, and archaea are truly the proverbial "big things come in small packages"—without these essential organisms, life as we know it wouldn’t exist.
As researchers, not only do we know how valuable microorganisms are with regard to human health and disease, but for finding solutions to numerous problems. That’s why ATCC scientists have collected, authenticated, and preserved organisms for nearly a century to ensure that researchers have access to the strains needed to develop vaccines, clean up oil spills, ensure healthier food and water, find treatments for infectious diseases, and develop products to keep our homes clean.
Explore our vast microbiology collection!
Read More